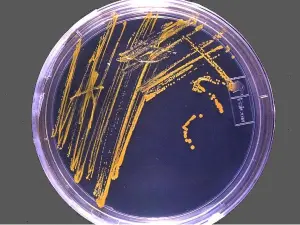
Чашка Петри с микроорганизмами, выделенными из губок в глубоких водных источниках Чашка Петри с микроорганизмами

Микробиология

Микробиология (греч. μικρος — малый, лат. bios — жизнь, лат. logos — учение) — наука, предметом изучения которой являются микроскопические существа, называемые микроорганизмами (микробами), включающими в себя:
- одноклеточные организмы,
- многоклеточные организмы и
- бесклеточные,
их биологические признаки и взаимоотношения с другими организмами, населяющими нашу планету.
В область интересов микробиологии входит их систематика, морфология, физиология, биохимия, эволюция, роль в экосистемах, а также возможности практического использования.
Разделы микробиологии:
- бактериология,
- микология,
- вирусология,
- паразитология
- и другие.
В зависимости от экологических особенностей микроорганизмов, условий их обитания, сложившихся отношений с окружающей средой и практических потребностей человека, наука о микроорганизмах в своем развитии дифференцировалась на такие специальные дисциплины, как общая микробиология, медицинская, промышленная (техническая), космическая, геологическая, сельскохозяйственная и ветеринарная микробиология.
Россиянин госпитализирован с подозрением на новый коронавирус
В Санкт-Петербурге в среду с подозрением на новый коронавирус были госпитализированы два человека – один граждан Китая и один россиянин. У пассажира, прилетевшего из Китая, как стало известно позднее, подозрения на заболевание не подтвердились. О диагнозе россиянина пока не сообщается. Известно, что это 23-летний Арман Каракешишян. Он прилетел в Петербург из Шанхая с пересадками в Красноярске и Москве. После приземления его с температурой тела 38 градусов увезла скорая помощь. При этом как минимум один из медиков, по данным телеграм-канала, был в костюме биологической защиты. Новый коронавирус, которым, возможно, заболел россиянин, появился в Китае. Там от него умерли уже 17 человек. При этом общее количество заболевших исчисляется сотнями, а накануне первый случай заболевания был подтвержден на территории США. Заражения также зафиксированы в Южной Корее, Таиланде и Японии. По сообщениям СМИ, неизвестный ранее…
В США – первый случай заболевания, вызванного новым коронавирусом
В Соединённых Штатах зафиксирован первый случай инфекции, вызываемой коронавирусом ранее не известного типа. Сообщается, что больной на прошлой неделе прилетел в Сиэтл из Китая, где произошла вспышка заболевания. У него была диагностирована пневмония, тесты подтвердили, что она вызвана новым коронавирусом. Американский Центр контроля и профилактики заболеваний заявил, что не исключает новых случаев заболеваний в ближайшие дни. В ряде аэропортов США начался скрининг пассажиров, прибывающих из Китая: проверяют, нет ли у них высокой температуры. По официальным данным, число умерших в Китае в результате инфекции, вызванной коронавирусом…
В Китае заметно увеличилось число инфицированных новым вирусом
В Китае медики подтвердили, что коронавирус нового типа, вызвавший вспышку пневмонии в стране, способен передаваться от человека к человеку. Это доказано применительно к двум случаям заболевания в провинции Гуандун, заявили 20 января эксперты Государственного комитета здравоохранения Китая. Они также подтвердил факты заражения вирусом, отмеченные среди сотрудников учреждений, в которых находятся больные, – заболели 14 медицинских работников. Учёные, однако, пока не могут…


